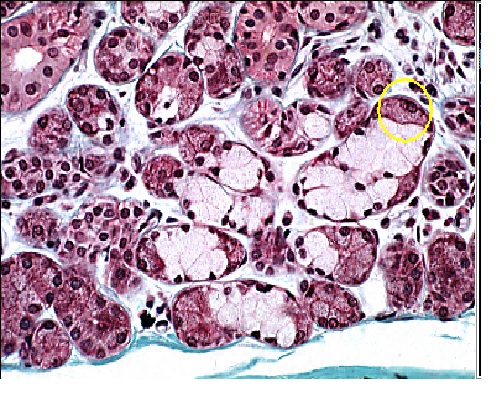

Le Guide pour bien débuter la LAS : Ici
Tutoriel Forum : Ici
Planning des Séances Tutorat et EB : ICI !
Errata : Séances Tutorat et EB, Annatuts, Ronéos
Centres de Téléchargement : ICI !
Réponses des Profs : ICI !
Annales : Achat, Corrections Officieuses
Annatuts : 2025-2026, Sommaire
MCC 25/26 : ICI
Candidature MMOPK : ICI
Terminale Santé : ICI
GROUPES ET INFOS ATELIERS RENFORCES : Ici
INSCRIPTIONS ENTRETIENS TUTEURS : Ici
Newsletter : ICI
Tutoriel Forum : Ici
Planning des Séances Tutorat et EB : ICI !
Errata : Séances Tutorat et EB, Annatuts, Ronéos
Centres de Téléchargement : ICI !
Réponses des Profs : ICI !
Annales : Achat, Corrections Officieuses
Annatuts : 2025-2026, Sommaire
MCC 25/26 : ICI
Candidature MMOPK : ICI
Terminale Santé : ICI
GROUPES ET INFOS ATELIERS RENFORCES : Ici
INSCRIPTIONS ENTRETIENS TUTEURS : Ici
Newsletter : ICI
QCM 11 tutorat 4
53 messages
• Page 3 sur 3 • 1, 2, 3
Re: QCM 11 tutorat 4
J'avoue que ne voyant que dalle a la zone entourée je me suis dis que ça devait être les mêmes que ceux qu'on voyait a côté ...
- Papa Ours
- Trésorier
- Messages: 395
- Inscription: 24 Aoû 2013, 10:45
Re: QCM 11 tutorat 4
Papa Ours a écrit:J'avoue que ne voyant que dalle a la zone entourée je me suis dis que ça devait être les mêmes que ceux qu'on voyait a côté ...
J'ai résonné exactement de la même façon !
-

A.P - Carabin confirmé
- Messages: 89
- Inscription: 27 Sep 2013, 19:11
Re: QCM 11 tutorat 4
pika-pikachu a écrit:désolé mais la ou ya la flèche les 3 cellules violettes ont leurs noyau repoussé en périphérie et non pas au milieu
Certes, mais si tu as un croissant , il est forcément séreux donc tu as forcément un acinus mixte, qu'est-ce qu'il ferait là sinon ? Et pour le noyau, c'est une généralité de dire qu'il est au milieu, lorsqu'on parle d'acinus séreux tout seul ! Mais quand il est mixte ça a l'air de ne plus être si vrai, regarde ça :
Après j'en convient tout à fait tout à fait, on ne voit pas très bien sur l'image du QCM en question. En couleur c'est toujours mieux.
Ups1502 a écrit:+1, ce qui est marrant c'est que c'est le seul acinus où on a un doute sur la position de la lumière, et le " croissant " en haut je pense honnêtement qu'il faut savoir pour le voir
Au sujet de la lumière de l'acinus, quand c'est mixte, d'après ce que j'ai remarqué on ne la voit pas au centre comme dans un acinus muqueux "normal" je me suis basé sur ça. Extrapolation personelle, ça a marché pour cette fois..
Breeeeeef, j'espère vous avoir un peu aidé, sinon tant pis, bonne soirée !
Work all night on a drink of rum...
Daylight come and mi wan go home
Daylight come and mi wan go home
-

Harmonie - Carabin vétéran
- Messages: 357
- Inscription: 17 Mai 2012, 18:02
Re: QCM 11 tutorat 4
ouais merci c'est pas con m'enfin au niveau de la photo,je plussoie ceux qui se plaignent de la qualité ^^ je sort la même chose une fois par jour mais j'ai la politesse de tirer la chasse après..
-

Alpha HIEI - Carabin newbie
- Messages: 18
- Inscription: 16 Aoû 2013, 16:07
Re: QCM 11 tutorat 4
Alpha HIEI a écrit:ouais merci c'est pas con m'enfin au niveau de la photo,je plussoie ceux qui se plaignent de la qualité ^^ je sort la même chose une fois par jour mais j'ai la politesse de tirer la chasse après..
Je vais te demander de te calmer un peu. Je comprend que si vous avez des contestations à dire ou des explications à demander vous vous exprimiez, mais il ne faut pas aller trop loin quand même. En espérant que le forum redevienne un peu un lieu de politesse, et de respect envers tout le monde.
Bonne journée

-

germaine - Carabin addicted
- Messages: 1150
- Inscription: 02 Fév 2012, 18:02
Re: QCM 11 tutorat 4
Yep, le schéma est très moyen mais ce n'est pas une raison pour sortir des blagues déplacées.
TCS 2017
Co-Rédacteur - La Passoire 2015/2016
Ronéiste UE3B Biophy-Physio 2015/2016
Co-Auteur des Ficelles de la Bio' Cell' 2014/2015
Co-Rédacteur - Carabin déchaîné (Actu. Scientifiques) 2014/2015
Ronéiste UE3B Biophy-Physio 2014/2015
Co-Rédacteur - La Passoire 2015/2016
Ronéiste UE3B Biophy-Physio 2015/2016
Co-Auteur des Ficelles de la Bio' Cell' 2014/2015
Co-Rédacteur - Carabin déchaîné (Actu. Scientifiques) 2014/2015
Ronéiste UE3B Biophy-Physio 2014/2015
-

♦MC♦ - Carabin addicted
- Messages: 1794
- Inscription: 28 Juin 2012, 15:52
Re: QCM 11 tutorat 4
C'est quand même un peu un scandale de voir le travail des tuteurs déprécié par des blagues d'un si mauvais goût ! Les tuteurs passent des heures à nous faire ces qcms d'entraînement et passent sûrement 2x plus de temps à répondre aux whines et réclamations et à les corriger. Surtout quand ils se trompent, alors là... 200 P1 rageux leur font remarquer, faut pas non plus aller trop loin !
J'tiens à rappeler que le tutorat est bénévole, entièrement pris sur leur temps libre, qu'ils passent des heures à arpenter le fofo pour aider, à faire des qcms et des classements... On est quand même dans la fac de médecine la plus assistée de France avec tous nos soutiens de qualités, et certains trouvent le moyen d'être désagréable et agressifs. Si le tutorat ne vous convient pas faut pas venir, personne vous regrettera !
Je ne blâme pas ceux qui râlent, je le fais aussi ! C'est normal et c'est même bien tant que ça reste constructif et poli !
Sinon, même si la photo était dégueu, merci pour ce que vous faites, on vous le dit peut être pas assez souvent
EDIT : J'en reviens à l'idée d'interdir le Tutorat, le Forum et même les Ronéos à certains rageux ! Amicalement, Poutou carabins, tendresse et guimauve, j'vous aime ! JD
Amicalement, Poutou carabins, tendresse et guimauve, j'vous aime ! JD
J'tiens à rappeler que le tutorat est bénévole, entièrement pris sur leur temps libre, qu'ils passent des heures à arpenter le fofo pour aider, à faire des qcms et des classements... On est quand même dans la fac de médecine la plus assistée de France avec tous nos soutiens de qualités, et certains trouvent le moyen d'être désagréable et agressifs. Si le tutorat ne vous convient pas faut pas venir, personne vous regrettera !
Je ne blâme pas ceux qui râlent, je le fais aussi ! C'est normal et c'est même bien tant que ça reste constructif et poli !
Sinon, même si la photo était dégueu, merci pour ce que vous faites, on vous le dit peut être pas assez souvent

EDIT : J'en reviens à l'idée d'interdir le Tutorat, le Forum et même les Ronéos à certains rageux !
 Amicalement, Poutou carabins, tendresse et guimauve, j'vous aime ! JD
Amicalement, Poutou carabins, tendresse et guimauve, j'vous aime ! JD-

JD - Carabin No Life
- Messages: 967
- Inscription: 11 Sep 2013, 16:45
- Localisation: Cul-De-Sac
Re: QCM 11 tutorat 4
Est-ce que qqun peut me montre où est la lumière sur l'image de Harmonie ?
Merci !
Merci !
-

Ups1502 - Apprenti Carabin
- Messages: 130
- Inscription: 19 Aoû 2013, 02:27
Re: QCM 11 tutorat 4
La différence de couleur est infime on passe du rose pâle au blanc, juste au dessous du rond jaune !
-

JD - Carabin No Life
- Messages: 967
- Inscription: 11 Sep 2013, 16:45
- Localisation: Cul-De-Sac
Re: QCM 11 tutorat 4
JD c'est en noir et blanc au tut 
- ASAT
- Carabin addicted
- Messages: 1216
- Inscription: 20 Aoû 2012, 22:37
Re: QCM 11 tutorat 4
Et puis de toute manière tout le monde aura faux à ce qcm donc ça va STRICTEMENT rien changer au classement donc no stress,un piege reste un piege et puis basta. 

Soyons sérieux, restons allumés !
-

Happiness - Carabin No Life
- Messages: 869
- Inscription: 04 Juil 2012, 08:54
Re: QCM 11 tutorat 4
Ce que tu soulèves n'est pas faux ASAT :p Je croyais que la question portait sur l'image en couleur plus haut !
-

JD - Carabin No Life
- Messages: 967
- Inscription: 11 Sep 2013, 16:45
- Localisation: Cul-De-Sac
Re: QCM 11 tutorat 4
Re,
nous avons dicuté avec le professeur Philip ce matin et je lui ai montré la photo (en noir et blanc directement sur un sujet du tutorat), certes, elle n'est pas très jolie et pas très claire mais le prof a vu que c'était une glande mixte et a remarqué sur la gauche de la structure des cellules avec un noyau central.
C'est vrai que cette photo n'est pas top, mais le QCM reste encore faisable, je ne vais donc pas l'annuler.
je tiens à remercier tous ceux qui nous soutiennent, c'est vraiment gentil à vous
Bonne journée
nous avons dicuté avec le professeur Philip ce matin et je lui ai montré la photo (en noir et blanc directement sur un sujet du tutorat), certes, elle n'est pas très jolie et pas très claire mais le prof a vu que c'était une glande mixte et a remarqué sur la gauche de la structure des cellules avec un noyau central.
C'est vrai que cette photo n'est pas top, mais le QCM reste encore faisable, je ne vais donc pas l'annuler.
je tiens à remercier tous ceux qui nous soutiennent, c'est vraiment gentil à vous

Bonne journée

-
germaine - Carabin addicted
- Messages: 1150
- Inscription: 02 Fév 2012, 18:02
53 messages
• Page 3 sur 3 • 1, 2, 3
Qui est en ligne
Utilisateurs parcourant ce forum: Aucun utilisateur enregistré et 2 invités
 Petit Ourson pour les intimes
Petit Ourson pour les intimes 

